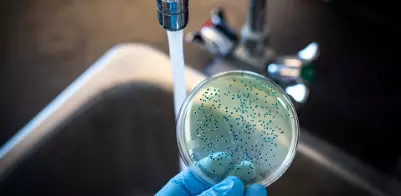

해외여행물갈이 일명 여행자설사란 무엇인가요?
안녕하세요 오늘은 해외여행 시 갑자기 배탈이나 설사 / 소화불량이 찾아왔을 때 어떻게 대처해야 하는지 그리고
예방하는 방법에 대해 알아보려고 합니다
그럼 해외여행시 이러한 증상이 왜 나타나는지 알아보자면 해외여행 중 오염된 물이나 음식의 섭취로 인해
대장균에 감염되어서 일명 여행자설사 증상을 보이는 것을 말합니다

여행자설사의 증상과 대처법에 대해 알아보기
해외여행에서 장염증상을 일으키는 제일 큰 원인은 바로 얼음 / 물 / 길거리음식이라고 합니다
그중 얼음이 가장 큰 요인인데 현지물을 그대로 얼려 사용한 것으로 장염을 많이 일으킨다고 합니다
그래서 해외여행시 될 수 있으면 물 섭취를 생수로 섭취해야 이를 예방할 수 있습니다

해외여행 물갈이 예방하는 방법 알아보기
즐거운 마음으로 해외여행을 떠났는데 물갈이등 복통이나 설사를 하게 되면 즐거웠던 여행의 기분이
다운되기 마련입니다
그래서 이왕이면 건강한 상태로 여행을 해야하기에 물갈이 예방법을 알고 지키시면 보다 건강하게
해외여행을 즐기실 수 있을것이라 생각이 됩니다

해외여행 시 반드시 챙겨가야 하는 비상약품 알아보기
해외여행 시에 다치거나 아플 수도 있는 비상상황을 대비하여 비상약품을 챙겨가야 합니다
아래의 리스트를 참고하여 비상약품을 미리 챙기시면 좋을 것 같습니다

에너지캐시백 전기세환급 한국전력공사 전기요금 캐쉬백신청방법
에너지캐시백이란 무엇인가요? 안녕하세요 한국전력공사에서 가정마다 에너지절감을 해서 전기를 절약한 집마다 에너지캐시백이라는 걸 신청할 수 있습니다 이는 현금으로 돌려주는 에너지캐
eunryul0329.com
신생아예방접종 질병관리청 예방접종도우미 건강인 영유아검진 예방접종증명서
질병관리청에서 제공하는 예방접종도우미사이트란 무엇인가요? 안녕하세요 오늘은 신생아부터 유아까지 국가에서 권고하는 예방접종에 대해 알아보려고 합니다 예방접종을 가장 많이 하는 신
eunryul0329.com
'여행의모든것' 카테고리의 다른 글
| 오션월드 오션월드할인 국민카드 kbpay 오션월드종일권 소노호텔앤리조트 (2) | 2023.07.04 |
|---|---|
| 캠핑준비물 캠핑음식 캠핑요리 여름캠핑준비물 초보캠핑 타프 모기퇴치 (1) | 2023.06.17 |
| 하리보 하리보전시회 하리보굿즈 인사동 인사센트럴뮤지엄 하리보월드 (2) | 2023.05.28 |
| 와이파이 에그 kt로밍 로밍에그 인천공항 kt로밍센터 일본로밍 (1) | 2023.05.23 |
| 태국여행 태국빠이 싸이응암온천 아주사적인동남아 유토피아 빠이 (2) | 2023.05.15 |




댓글